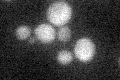
YBL031W
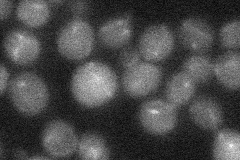
YBL031W
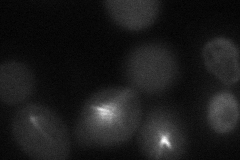
YBL031W
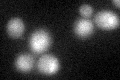
YBL031W
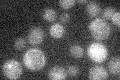
YBL031W

View description
Mitotic spindle protein that interacts with components of the Dam1 (DASH) complex, its effector Sli15p, and microtubule-associated protein Bim1p; also localizes to nuclear microtubules and to the bud neck in a ring-shaped structure
Localization:
Intensity:
Fold change:
Significance:
-
C’ GFP library in SD
below threshold17.93 -
N' NOP1pr-GFP in SD

punctate60.156 -
N' TEF2pr-mCherry in SD

punctate27.4191 -
N' NATIVEpr-GFP in SD
punctate20.4455 -
N' TEF2pr-VC and Cyto-VN in SD
punctate40.2997 -
C’ GFP library in SD+DTT
cytosol18.911.05No -
C’ GFP library in SD+H2O2

cytosol17.120.95No -
C’ GFP library in Starvation Media
cytosol15.840.88No -
C’ GFP library on the background of Pup2-DaMP

below threshold -
C’ GFP library on the background of CCT mutant

below threshold18.08571.00795No
